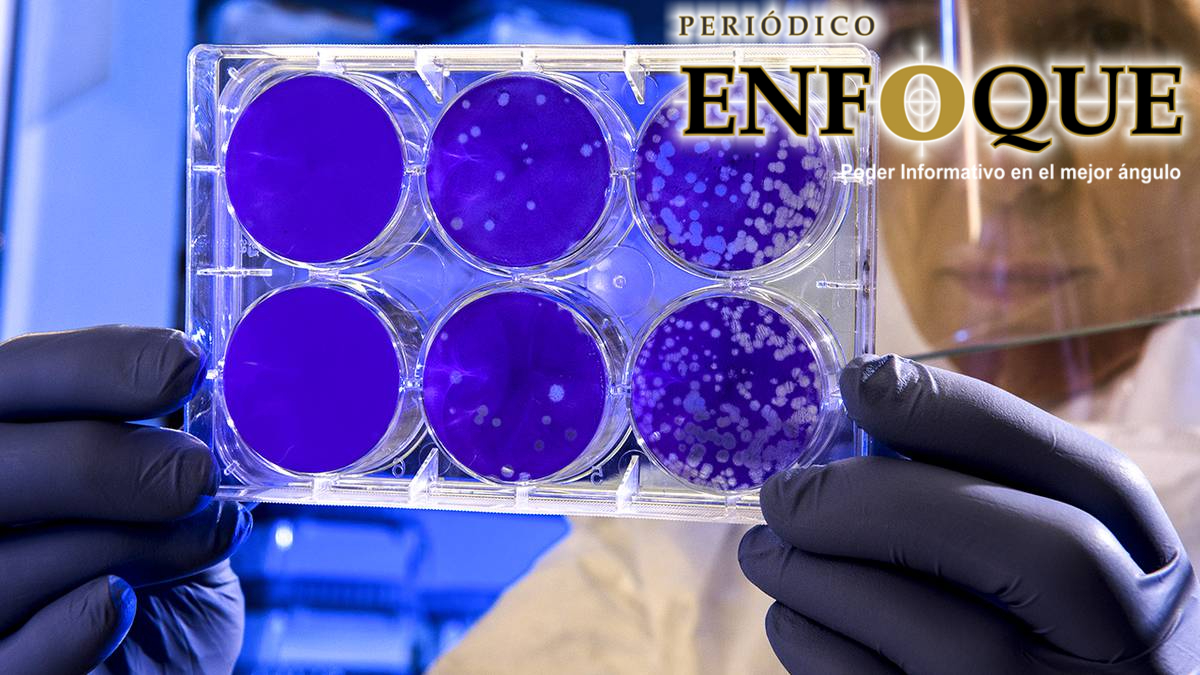

La nueva cepa nombrada bajo el código científico como B117 (o también VUI-202012/01), ha causado un aumento sin precedentes en el número de casos en el país inglés y se ha convertido en la variante predominante y la de temer en apenas tres meses.
A finales del año pasado se estima que el 60% de los nuevos casos en Londres y regiones aledañas corresponden a la nueva variante de este mal patógeno.
Según un estudio del Imperial College de Londres, la nueva cepa es 50% más contagiosa que otras, y esto eleva el número que representa el número de personas promedio a las que una persona infectada puede contagiar es decir que de 0,4 de la cepa normal pasa a un y 0,7 de personas con esta nueva variante.
Todavía no está exactamente calara el mecanismo que emplea la cepa para lograrlo. Pero estudios apuntan a que una de las 17 mutaciones más importantes (en la proteína en forma de espiga del virus) le permite al virus asentarse mejor a una proteína en la superficie de las células humanas, facilitando así la posible infección.
Otra hipótesis que se maneja es que esto depende de la carga viral ya que en el 35% de las muestras de pacientes infectados con la cepa B117 estos contaban con altos niveles del virus en su cuerpo, en comparación con solo un 10% de los pacientes infectados con otra variante del nuevo Coronavirus.
Menú
 Periódico Enfoque
Poder Informativo en el Mejor Ángulo
Periódico Enfoque
Poder Informativo en el Mejor Ángulo
13
Sáb, Dic
8
New Articles